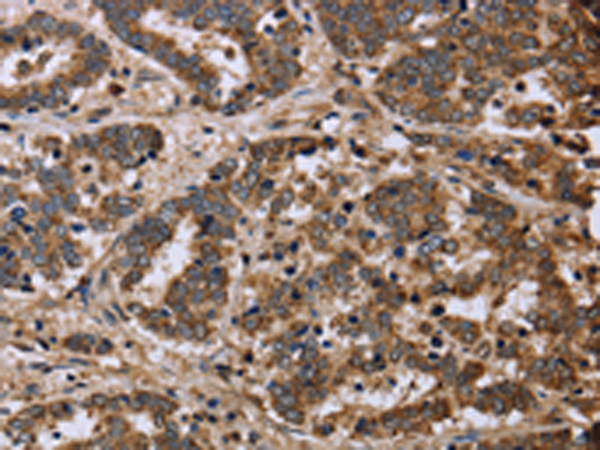

|
Background: |
The protein encoded by this gene is an enzymatic component of the tricarboxylic acid (TCA) cycle, or Krebs cycle, and catalyzes the formation of L-malate from fumarate. It exists in both a cytosolic form and an N-terminal extended form, differing only in the translation start site used. The N-terminal extended form is targeted to the mitochondrion, where the removal of the extension generates the same form as in the cytoplasm. It is similar to some thermostable class II fumarases and functions as a homotetramer. Mutations in this gene can cause fumarase deficiency and lead to progressive encephalopathy. |
|
Applications: |
ELISA, WB, IHC |
|
Name of antibody: |
FH |
|
Immunogen: |
Fusion protein of human FH |
|
Full name: |
fumarate hydratase |
|
Synonyms: |
MCL; LRCC; HLRCC; MCUL1 |
|
SwissProt: |
P07954 |
|
ELISA Recommended dilution: |
2000-5000 |
|
IHC positive control: |
Human liver cancer |
|
IHC Recommend dilution: |
50-200 |
|
WB Predicted band size: |
55 kDa |
|
WB Positive control: |
Mouse liver, brain and heart tissue, RAW264.7 cells |
|
WB Recommended dilution: |
500-2000 |

購物車
幫助
021-54845833/15800441009
